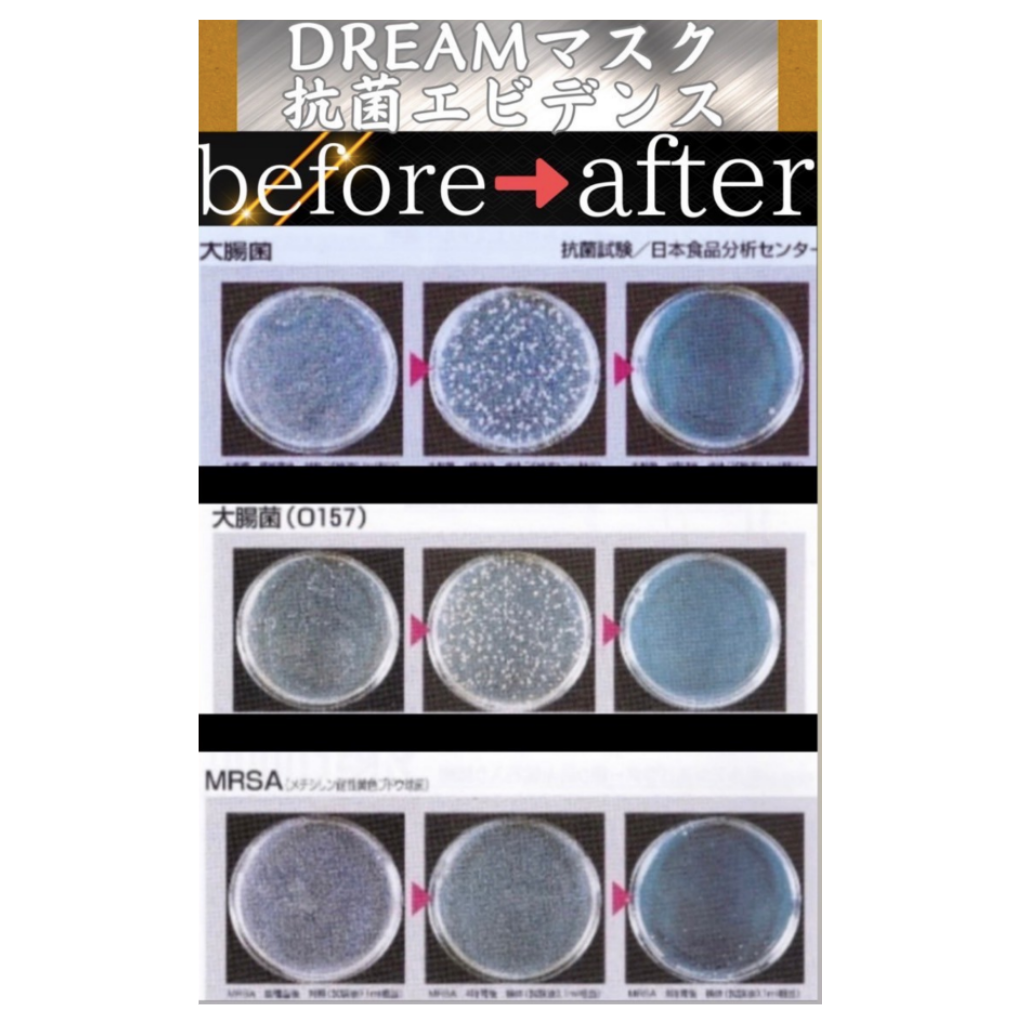

Products Crafted with the Pinnacle of Antibacterial Technology
The Antibacterial Product Manufacturing Solutions division of Tendai Co., Ltd. provides products that have cleared antibacterial testing at the world’s highest standards.
Our products incorporate antibacterial technology into every item used in daily life — supporting both hygiene and health in all aspects of living.
Furthermore, the moisture-wicking, quick-drying fibers and platinum nanoparticles used in our products are anticipated to deliver both enhanced comfort and improved immune function.

Effectiveness Proven Through Antibacterial Testing
All of our products have cleared rigorous antibacterial testing and have obtained supporting evidence. This ensures that antibacterial performance is maintained over long periods of use — supporting a hygienic and healthy lifestyle.
Every product incorporates ingredients that contribute to enhanced immune function, with additional anticipated benefits including a body temperature-raising effect.

The Antibacterial Series Product Lineup
▪️Antibacterial Toothbrush
A toothbrush with outstanding antibacterial effects and gum care — keeping your oral environment clean and fresh through daily care.


▪️Antibacterial Mask Cover
A mask cover that prevents the intrusion of viruses and bacteria — maintaining comfort even during extended periods of use.
▪️Antibacterial Towel & Bath Towel
Towels with excellent absorbency and quick-drying properties — keeping you clean and hygienic. Gentle on the skin thanks to antibacterial effects — safe and reassuring to use with complete confidence.
▪️Antibacterial Socks
Socks crafted to protect the health of your feet — suppressing the causes of odor through antibacterial effects and maintaining a sense of cleanliness for extended periods.

▪️Antibacterial T-Shirt, Trunks & Lingerie Pants
Clothing that is gentle on the skin, with outstanding moisture-wicking and quick-drying properties, combined with powerful antibacterial functionality. Utilizing platinum nanoparticles, these garments contribute to enhanced immune function through a body temperature-raising effect.

Embracing a New Way of Life with Antibacterial Products
The items you use every single day protect your health.
The Antibacterial Series of Tendai Co., Ltd. provides scientifically proven safety and health maintenance functions — offering effortless support for health maintenance within the flow of everyday life.
Please do not hesitate to try our antibacterial products — safe, reassuring, and ready to be experienced.
